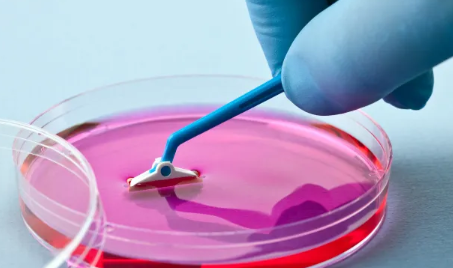
image.png

河北生物干細(xì)胞存儲(chǔ)公司有哪些
2024-09-10 10:20:51 來(lái)源: 小編 咨詢醫(yī)生
隨著生物技術(shù)的不斷進(jìn)步,干細(xì)胞的研究和應(yīng)用日益受到關(guān)注。干細(xì)胞因其獨(dú)特的分化潛能被廣泛應(yīng)用于再生醫(yī)學(xué)、組織工程和疾病治療等領(lǐng)域。
1.河北生物干細(xì)胞存儲(chǔ)公司的背景
河北省作為中國(guó)的一個(gè)重要省份,擁有多家專(zhuān)注于干細(xì)胞存儲(chǔ)和研究的公司。這些公司致力于為客戶提供高質(zhì)量的干細(xì)胞存儲(chǔ)服務(wù),為未來(lái)的醫(yī)療需求打下堅(jiān)實(shí)基礎(chǔ)。
2.主要生物干細(xì)胞存儲(chǔ)公司
2.1河北省細(xì)胞醫(yī)學(xué)研究院
河北省細(xì)胞醫(yī)學(xué)研究院專(zhuān)注于干細(xì)胞的研究和應(yīng)用,提供包括臍帶血和胎盤(pán)血干細(xì)胞的存儲(chǔ)服務(wù)。該院憑借強(qiáng)大的科研背景,致力于干細(xì)胞在臨床醫(yī)學(xué)中的應(yīng)用,為客戶提供安全可靠的存儲(chǔ)方案。
2.2河北紅十字臍帶血管理中心
作為省內(nèi)權(quán)威的干細(xì)胞存儲(chǔ)機(jī)構(gòu),河北紅十字臍帶血管理中心主要涉及臍帶血的收集和存儲(chǔ)。該中心根據(jù)國(guó)際標(biāo)準(zhǔn)進(jìn)行操作,確保存儲(chǔ)的臍帶血干細(xì)胞的安全性與有效性,致力于為臨床使用提供支持。
2.3河北晨光細(xì)胞技術(shù)有限公司
河北晨光細(xì)胞技術(shù)有限公司是一家以干細(xì)胞技術(shù)為核心的生物技術(shù)企業(yè),提供多種類(lèi)型的干細(xì)胞存儲(chǔ)服務(wù),重點(diǎn)在于人源性干細(xì)胞的研究與應(yīng)用。該公司擁有先進(jìn)的實(shí)驗(yàn)室設(shè)備和技術(shù)團(tuán)隊(duì),致力于開(kāi)發(fā)新型的干細(xì)胞治療方案。
3.存儲(chǔ)技術(shù)與服務(wù)
大多數(shù)河北生物干細(xì)胞存儲(chǔ)公司都采用國(guó)際先進(jìn)的存儲(chǔ)技術(shù),包括低溫冷凍和超低溫冷庫(kù)存儲(chǔ),通過(guò)氮?dú)饫鋬龅确绞酱_保細(xì)胞的活性和純度。此外,公司通常還提供定期的質(zhì)量檢測(cè)服務(wù),確保存儲(chǔ)細(xì)胞的安全性和可靠性。
4.選擇生物干細(xì)胞存儲(chǔ)公司的注意事項(xiàng)
資質(zhì)認(rèn)證:選擇經(jīng)過(guò)國(guó)家相關(guān)部門(mén)認(rèn)證的干細(xì)胞存儲(chǔ)公司,以確保服務(wù)的合法性和專(zhuān)業(yè)性。
存儲(chǔ)技術(shù):了解公司使用的存儲(chǔ)技術(shù),是否符合國(guó)際標(biāo)準(zhǔn)及行業(yè)規(guī)范。
臨床應(yīng)用:咨詢公司關(guān)于干細(xì)胞的臨床應(yīng)用實(shí)例和成功案例,判斷其專(zhuān)業(yè)能力。
售后服務(wù):良好的售后服務(wù)能夠?yàn)榭蛻籼峁╅L(zhǎng)久的保障,確保在需要時(shí)能夠及時(shí)取得存儲(chǔ)的干細(xì)胞。
5.未來(lái)的發(fā)展趨勢(shì)
隨著醫(yī)學(xué)技術(shù)的不斷進(jìn)步和人們對(duì)健康的重視,生物干細(xì)胞存儲(chǔ)行業(yè)將繼續(xù)發(fā)展。河北生物干細(xì)胞存儲(chǔ)公司將在技術(shù)研發(fā)、市場(chǎng)拓展和用戶服務(wù)等方面不斷創(chuàng)新,以滿足日益增長(zhǎng)的市場(chǎng)需求。此外,結(jié)合人工智能、大數(shù)據(jù)等新技術(shù),未來(lái)的干細(xì)胞存儲(chǔ)與應(yīng)用將更加智能化和高效化。
6.結(jié)語(yǔ)
綜上所述,河北省的生物干細(xì)胞存儲(chǔ)公司在市場(chǎng)中扮演著重要角色,為保障人類(lèi)健康作出了積極貢獻(xiàn)。在選擇相關(guān)服務(wù)時(shí),消費(fèi)者應(yīng)對(duì)公司進(jìn)行全面了解,以確保選擇到最適合的存儲(chǔ)方案。
- 2024-10-16儲(chǔ)存干細(xì)胞哪個(gè)機(jī)構(gòu)好?哪家服務(wù)質(zhì)量更高?
- 2024-07-30臍帶間充質(zhì)干細(xì)胞存儲(chǔ)費(fèi)用,臍帶間充質(zhì)干細(xì)胞需要配型嗎
- 2024-08-04臍帶干細(xì)胞存儲(chǔ)要多少錢(qián),臍帶干細(xì)胞存儲(chǔ)流程
- 2024-11-11如何存儲(chǔ)自體脂肪干細(xì)胞更有效,儲(chǔ)存條件及年限
- 2024-08-22為什么要存儲(chǔ)臍帶干細(xì)胞,詳解其儲(chǔ)存必要性
- 2024-10-26上海孟超干細(xì)胞存儲(chǔ):怎樣確保安全存儲(chǔ)?
- 2024-08-08蘋(píng)果干細(xì)胞是什么功效,蘋(píng)果干細(xì)胞真能美容嗎
- 2024-09-23捐造血干細(xì)胞有補(bǔ)嘗嗎,捐獻(xiàn)造血干細(xì)胞的補(bǔ)償
- 2024-08-07干細(xì)胞生發(fā)技術(shù),干細(xì)胞生發(fā)技術(shù)成熟嗎
- 2024-09-07干細(xì)胞治療新冠肺炎進(jìn)展,干細(xì)胞如何對(duì)付新冠病毒
- 2024-09-06臍帶干細(xì)胞抗衰老有效果嗎,可以保持幾年
- 2024-08-28甲狀腺結(jié)節(jié)用干細(xì)胞療法有用嗎多少錢(qián)
- 2024-08-22神經(jīng)干細(xì)胞研究進(jìn)展最新匯總
- 2024-09-01蘋(píng)果干細(xì)胞的作用原理和實(shí)際運(yùn)用
- 2024-10-08鹽城干細(xì)胞價(jià)格是多少?與效果有何關(guān)聯(lián)?
- 2024-09-06干細(xì)胞具有什么功效,詳解主要功效和副作用
- 2024-09-20福州總醫(yī)院干細(xì)胞移植費(fèi)用多少錢(qián)
- 2024-09-05干細(xì)胞填充價(jià)格多少,附費(fèi)用影響因素
